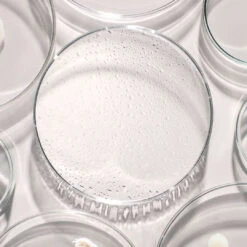
Codex Labs Antu Radiance Mist 9 Codex Labs Antu Radiance Mist -Cosmetics Store Codex Beauty Labs Antu Radiance Mist3

$47.00 Original price was: $47.00.$32.90Current price is: $32.90.
- Experience Quality, Shop with Us
- Unbeatable quality, unbeatable prices.
- Safe and Secure Shopping
- 7-Day Returns, 100% Quality

Refresh tired, dehydrated skin in a relaxing veil of moisture (over or under makeup) with Codex Lab’s Antu Radiance Mist. Formulated with breakthrough biotech ingredients including their patent-pending, potent AntüComplex™ to decrease the appearance of pores and freshen up the skin throughout the day.
Clinically proven to refine the appearance of pores, Codex Lab’s Antü Radiance Mist uses key actives like M3 Antioxidants, Hyaluronic Acid, and Hydroxy Acids (AHA) to improve dull, dry, tired, or uneven skin. Clinical data results determined that 94% of subjects experienced a 49% increase in hydration, 76% of subjects experienced a 14% decrease in pore visibility, and 91% experienced a 21% increase in overall smoothness.
Benefits of Codex Lab’s Antu Radiance Mist:
- Toning
- Refining
- Hydrating
Key Ingredients:
- ANTUCOMPLEX™: Powerful antioxidant mix
- MANGO: Exfoliates with AHA, tones, and helps firm
Help soothe, hydrate and exfoliate your skin with Codex Lab’s Antu Radiance Mist. Made with the brand’s iconic ANTUCOMPLEX™, this soothing mist is non-irritating and quenches itchy, thirsty skin with a surge of moisture. Infused with Biotech ingredients, this facial mist is clinically proven to refine the appearance of pores and has been created for all skin types, including dull, dry, uneven or tired skin. Can be used alone, over or under makeup for an instant skin pick-me-up throughout the day.
How to use:
Shake well before use. Spray onto the face (with closed eyes) at arm’s length. For daily use, anytime and anywhere, under or over makeup. Suitable for all skin types.
Size: 50ml & 100ml
Please note: This product is not recommended for anyone with an allergy for Linalool, Citral and Limonene.
| Size | 100ml, 30ml |
|---|
Be the first to review “Codex Labs Antu Radiance Mist” Cancel reply
Related products
Night Care
Vichy Liftactiv Collagen Specialist Peptide Night Cream With Reservatrol For All Skin Types 50ml
Eyeshadow
Night Care
Night Care
Night Care
Skincare

Reviews
There are no reviews yet.